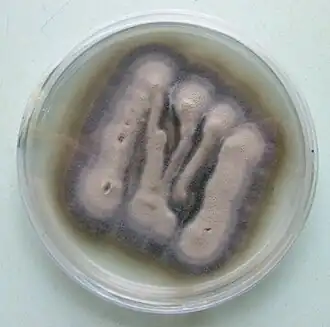
Description de cette image, également commentée ci-après

Plectosphaerellaceae
Plectosphaerellaceae
Culture de Verticillium theobromae sur milieu de gélose dextrosée à la pomme de terre
| Règne | Fungi |
|---|---|
| Sous-règne | Dikarya |
| Division | Ascomycota |
| Sous-division | Pezizomycotina |
| Classe | Sordariomycetes |
| Sous-classe | Hypocreomycetidae |
| Ordre | Glomerellales |
Les Plectosphaerellaceae sont une famille de champignon ascomycètes de la classe des Sordariomycetes.
Cette famille comprend plusieurs genres de champignons phytopathogènes dont le plus important sur le plan économique est Verticillium.
Liste des genres
Selon Catalogue of Life (16 octobre 2014)[1] :
- genre Gibellulopsis
- genre Lectera
- genre Musicillium
- genre Plectosphaerella
- genre Spermosporina
- genre Verticillium
Liste des genres, espèces et non-classés
Selon NCBI (16 octobre 2014)[2] :
- genre Lectera
- Lectera colletotrichoides
- Lectera longa
- genre Plectosphaerella
- Plectosphaerella alismatis
- Plectosphaerella citrullae
- Plectosphaerella cucumerina
- Plectosphaerella melonis
- Plectosphaerella oligotrophica
- Plectosphaerella pauciseptata
- Plectosphaerella plurivora
- Plectosphaerella ramiseptata
- genre Sodiomyces
- Sodiomyces alkalinus
- non-classé Sodiomyces alkalinus F11
- Sodiomyces alkalinus
- non-classé mitosporic Plectosphaerellaceae
- genre Acremonium
- Acremonium alcalophilum
- non-classé Acremonium alcalophilum JCM 7366
- Acremonium antarcticum
- Acremonium brunnescens
- Acremonium cucurbitacearum
- Acremonium furcatum
- Acremonium nepalense
- Acremonium restrictum
- Acremonium stromaticum
- Acremonium alcalophilum
- genre Acrostalagmus
- Acrostalagmus annulatus
- Acrostalagmus luteoalbus
- genre Gibellulopsis
- Gibellulopsis nigrescens
- Gibellulopsis piscis
- genre Musicillium
- Musicillium theobromae
- genre Stachylidium
- Stachylidium bicolor
- genre Verticillium
- Verticillium albo-atrum
- Verticillium alfalfae
- non-classé Verticillium alfalfae VaMs.102
- Verticillium dahliae
- non-classé Verticillium dahliae JR2
- non-classé Verticillium dahliae VDG1
- non-classé Verticillium dahliae VDG2
- non-classé Verticillium dahliae VdLs.17
- Verticillium isaacii
- Verticillium klebahnii
- Verticillium longisporum
- Verticillium nonalfalfae
- Verticillium nubilum
- Verticillium tricorpus
- non-classé Verticillium tricorpus MUCL 9792
- Verticillium zaregamsianum
- genre Acremonium
Notes et références
Liens externes
- (en) Catalogue of Life : Plectosphaerellaceae (consulté le )
- (en) Index Fungorum : Plectosphaerellaceae W. Gams, Summerb. & Zare 2007 (+ MycoBank) (consulté le )
- (fr + en) ITIS : Plectosphaerellaceae (consulté le )
- (en) MycoBank : Plectosphaerellaceae W. Gams, Summerbell & Zare (consulté le )
- (en) NCBI : Plectosphaerellaceae (taxons inclus) (consulté le )
- Portail de la mycologie